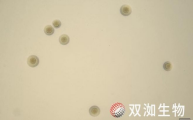
技术资料图片5

上海富衡生物科技有限公司品牌商
5 年
手机商铺
- NaN
- 0.20000000000000018
- 0.20000000000000018
- 2.2
- 2.2
上海富衡生物科技有限公司
入驻年限:5 年
- 联系人:
刘胜富
- 所在地区:
上海 闵行区
- 业务范围:
抗体、ELISA 试剂盒、细胞库 / 细胞培养、论文服务、试剂、实验室仪器 / 设备、技术服务、耗材
- 经营模式:
代理商 经销商 生产厂商 科研机构
推荐产品
技术资料/正文
上海富衡|细胞培养手册第一版(第四册)
166 人阅读发布时间:2025-03-14 15:03
六、细胞培养中的常见问题与解决方案
在细胞培养过程中,出现的最常见问题是各类微生物污染:
6.1.细菌污染
细菌污染是细胞培养中常见的问题,若不及时识别和处理,可能导致实验失败和资源浪费。以下是细菌污染的识别与处理方法:
 培养箱等微环境的除菌剂
培养箱等微环境的除菌剂
6.1.1 细菌污染的识别方法
6.1.1.1 显微镜观察
特征:在光学显微镜下,细菌通常表现为小而快速移动的颗粒,形状可以是球形(球菌)、杆状(杆菌)或螺旋形(螺旋菌)。这些颗粒通常比细胞小得多,并且在培养基中自由漂浮。
6.1.1.2 pH 变化
特征:细菌污染通常会导致培养基pH 值变化,常表现为pH 下降(酸性增加)。含酚红的培养基颜色会从红色变为黄色或橙色。
检测:通过培养基颜色的变化或pH 计测定,可以初步判断是否有细菌污染。
6.1.1.3 培养基的混浊
特征:细菌迅速生长会使培养基变得浑浊,尤其是在大规模污染时,更容易观察到。
检测:与未受污染的培养基对比观察,污染的培养基会显得不透明或含有絮状物。
6.1.1.4 细菌培养检测
步骤:取少量疑似污染的培养基涂布到 LB 琼脂平板或血琼脂平板上,并在 37° C 培养 24 小时,观察是否有菌落生长。
结果分析:一般来说,培养基被细菌污染后涂板,平板上细菌会成片生长,若只有个别菌落生长,可能只是操作污染。
6.1.1.5 细菌污染的处理方法
· 一旦确认污染,应立即弃掉污染的细胞培养物和培养基,以防扩散。
· 使用消毒剂(如 70% 乙醇或次氯酸钠)彻底清洁工作台面、培养箱、离心机等所有接触到污染样品的设备。
· 培养箱内尤其要彻底清洁和消毒,定期更换培养箱中的水槽水,确保不含污染物。
· 确认污染原因,杜绝下次重复发生,主要检查培养基、血清、耗材等无菌材料,更要注意实验操作技术,严格遵守无菌操作规程,大部分的实验室污染都是实验员的操作不当造成。
 细菌污染,200X,高倍镜下可见微小杆
细菌污染,200X,高倍镜下可见微小杆
 细菌污染,培养基发黄变浑菌
细菌污染,培养基发黄变浑菌
6.2 霉菌污染
霉菌污染是细胞培养中的另一种常见污染形式,霉菌可以快速扩散,危害细胞培养的健康。及时识别和处理霉菌污染至关重要。以下是霉菌污染的识别与处理方法:
6.2.1. 霉菌污染的识别方法
6.2.1.1 显微镜观察
特征:在显微镜下,霉菌通常表现为分支的丝状结构,称为菌丝(hyphae),有时还可以看到孢子(spores)或孢子囊(sporangia)。霉菌通常较大,明显不同于细菌的外观。
注意:霉菌的生长可以在细胞培养物表面或培养基中观察到,特别是在未搅动的培养瓶中。
6.2.1.1 肉眼观察
特征:霉菌污染往往能够肉眼观察到,表现为培养基表面或培养瓶壁上出现毛茸茸的、棉絮状的白色、绿色、黑色或灰色斑点或团块。
检测:霉菌斑块通常从小点开始,并迅速扩散形成更大的菌落。
6.2.1.2 培养基混浊和颜色变化
特征:霉菌污染可能会导致培养基变得浑浊,有时还伴有颜色变化,如发绿或发黑,具体取决于霉菌的种类。
检测:定期检查培养基的透明度和颜色变化,尤其在出现异味时要引起警觉。
6.2.1.3 pH 变化
特征:霉菌污染有时会引起培养基的 pH 值变化,常表现为 pH 值下降(酸性增加)。
检测:与细菌污染类似,观察含酚红的培养基颜色变化或使用 pH 计测定。
6.2.2 霉菌污染的处理方法
· 立即弃掉污染的培养物:一旦确认霉菌污染,应立即弃掉污染的细胞培养物和培养基,以避免霉菌孢子扩散至其他培养物或实验环境。
· 彻底清洁和消毒:使用消毒剂(如 70% 乙醇、次氯酸钠或专门的抗真菌剂)彻底清洁所有接触过污染培养物的设备和工具,包括工作台、生物安全柜、培养箱等。特别注意:在霉菌污染的情况下,应特别重视培养箱的清洁,因为霉菌孢子容易通过空气传播。清洗培养箱内的水槽,使用新鲜的无菌水。
· 更换培养耗材:所有可能受污染的耗材,如培养瓶、移液器吸头、培养皿等,应全部更换。对于一次性耗材,直接丢弃;对于可重复使用的工具,应进行高温高压灭菌或使用专用消毒剂处理。
· 改进无菌操作:严格遵守无菌操作规程,在生物安全柜中进行所有细胞操作,定期更换手套,使用经过灭菌处理的耗材和培养基。
· 定期环境监控:定期对培养室和培养设备进行环境监控,检测空气中的霉菌孢子浓度,并采取必要的措施降低霉菌污染风险。可以在培养箱中放置平板琼脂进行空气孢子检测。
6.2.3 预防霉菌污染
·使用抗真菌剂(如两性霉素B 或放*菌酮)可以在某些情况下预防霉菌污染。然而,这些药剂可能对某些细胞类型有毒性,使用时需谨慎。
· 在培养基中加入适量抗真菌剂,有助于防止霉菌污染,但应根据实验需求和细胞特性确定是否使用。
 霉菌污染,与细菌污染最大的区别是大多数霉菌不溶于水
霉菌污染,与细菌污染最大的区别是大多数霉菌不溶于水
6.3 支原体污染
支原体(Mycoplasma)污染是细胞培养中的隐性问题,因其小巧且无细胞壁,难以被传统抗生素清除。支原体污染不会导致显著的肉眼可见变化,但会对细胞的代谢、增殖、形态和实验结果产生重大影响。
支原体可以从被污染的细胞培养物中培养出来,但过程相对复杂,通常需要专门的方法和培养基。如 SP4 培养基或Freys 培养基,这些培养基中富含胆固醇、酵母提取物、血清等成分,以满足支原体的营养需求。
在固体培养基上,支原体形成的菌落
非常小,呈现“煎蛋样”或“火山口样”的形态。由于它们没有细胞壁,显微镜下很难用传统染色方法(如革兰氏染色)观察到。
因此,识别和处理支原体污染对于保
持细胞培养的健康至关重要。
(此图由扬州大学张小荣老师提供)
(此图由扬州大学张小荣老师提供)
6.3.1 支原体污染的识别方法
6.3.1.1 荧光染色法(DAPI 或 Hoechst 染色)
原理:支原体 DNA 在细胞外游离或附着于细胞膜上,通过特异性荧光染料如 DAPI 或 Hoechst 染色后,在显微镜下可以观察到胞外或胞内的亮点。
步骤:
· 将细胞固定在载玻片上。
· 用 DAPI 或 Hoechst 染料染色,并在荧光显微镜下观察。
· 若存在支原体污染,可在细胞周围或细胞内观察到散布的亮点。优点:快速、直观,可初步筛查支原体污染。
缺点:灵敏度有限,可能漏检低水平污染。
6.3.1.2 PCR 检测
原理:利用 PCR 扩增支原体特异性基因片段,检测细胞培养物中是否存在支原体 DNA。
步骤:
· 提取细胞培养物或培养上清中的 DNA。
· 使用支原体特异性引物进行 PCR 扩增。
· 通过电泳或荧光定量 PCR(qPCR)检测扩增产物,判断是否有支原体污染。 优点:灵敏度远高于染色法,配合核酸抽提方案,可检测到低至 10CFU/mL 的支原体污染。
缺点:需要专业设备和操作。
6.3.2 支原体污染的处理方法
6.3.2.1 丢弃污染的培养物
一旦确认支原体污染,应立即丢弃污染的细胞培养物、培养基和相关耗材,以防污染扩散。
6.3.2.2 清洁和消毒实验环境
使用消毒剂(如次氯酸钠或乙醇)彻底清洁所有接触过污染样品的设备和工作区域。
6.3.1.1 使用支原体去除试剂
目前市面上有一些专用的支原体去除试剂(如支原体消除剂),通过化学或生物学手段杀灭支原体。
· 将去除试剂加入污染的细胞培养物中,按说明
进行处理。
· 在处理完成后,使用支原体检测方法(如 PCR)验证去除效果。
优点:可以保留宝贵的细胞株,适用于污染较轻的情况。
缺点:可能存在残留污染,影响细胞性能,因此,如果支原体污染严重或去除不彻底,建议从冻存的无污染细胞库中重新复苏细胞,并重新开始培养。
 支原体清除试剂
支原体清除试剂
6.4“黑胶虫”污染
细胞培养中,细胞状态较差的时候,镜检可以发现细胞周围和培养液中出现许多点状或杆状的黑点和碎片,呈现布朗运动,和细菌污染非常相似,但培养基依然保持清澈状态,取出培养物,涂布 LB 平板培养,检测不到细菌生长,对此,很多人认为是“黑胶虫”污染。
关于“黑胶虫”,有很多解释,目前并无令人信服的答案:
· 血清中某类微生物污染导致,目前血清过滤,终端虑柱都是 100nm 孔径,包括支原体在内的微生物都会清除,所以这种说法可能性极低。
· 黑胶虫是指一类真菌,它们在培养基中会形成黑色或深棕色的菌落,同时有孢子产生,这种说法的依据是,一些含抗真菌药的“黑胶虫”清除剂有一定处理效果。
· 黑胶虫是支原体污染后细胞凋亡的碎片,因体积微小,表现出布朗运动。
· 细胞分泌的矿物质沉淀,涉及到细胞本身可能产生的不可溶矿物质,而不是外来的微生物污染。这种现象可能与细胞的代谢产物、细胞内外矿物质的沉积等因素有关。有证据表明,血清质量较差的情况下,更容易发生“黑胶虫”污染。
总之,“黑胶虫”污染的原因很多,鉴别难度大,时间成本高,一旦发生,建议直接丢弃细胞培养物,更换培养体系,特别是血清。如果细胞较为珍贵,可尝试用抗真菌药或抗支原体药物处理,同时更换质量可靠的胎牛血清和细胞培养基。
6.5 血清沉淀
目前的动物血清生产,大多数采取逐级过滤的方式,最终的过滤孔径一般是 100nm,因此,刚生产的血清,都是清澈无沉淀的。
新生牛血清,经过冷冻储存再解冻后,血清外观不会有明显变化,沉淀析出非常少。
胎牛血清,经过冷冻储存再解冻后,会有较多的蛋白沉淀,主要成分是纤维蛋白,此外磷酸钙、胆固醇、脂肪酸酯以及一些不溶性脂蛋白质,原因推测是胎牛的凝血功能不完整,胎牛血清在生产前的沉淀析出不完全,在长时间的储存过程中,会继续析出各种蛋白沉淀。
 胎牛血清解冻后自然析出的蛋白沉淀
胎牛血清解冻后自然析出的蛋白沉淀
6.5.1 血清沉淀的预防
使用前,在 4℃低温下解冻胎牛血清,可减少沉淀的析出,避免室温,甚至 37℃水浴锅解冻。
可使用商业化的小设备解冻胎牛血清,如血清融化仪,原理就是在 4℃条件下,缓慢摇晃解冻,最大程度减少沉淀的产生。
 血清融化仪缓慢解冻
血清融化仪缓慢解冻
6.5.2 血清沉淀的处理
蛋白沉淀并不影响血清的质量,但过多的话影响细胞的观察。因此可对沉淀做一些简单的处理:
· 融化的血清静置 30 分钟,待蛋白沉淀全部沉降到血清底部(严禁剧烈摇晃瓶子,蛋白沉淀一旦成为细小的颗粒、片状、絮状,很难再沉降)。
· 准备一个无菌的 500ml 血清瓶或培养基瓶,将血清缓慢转移其中,留最后 10- 20ml 左右血清和沉淀 ( 血清刚解冻时会分层,此时不适宜直接分装 )。
· 将最后 10-20ml 血清转移到离心管中,2000rpm 离心 5 分钟,弃沉淀即可。

 血清中的蛋白沉淀,40X
血清中的蛋白沉淀,40X
在低倍镜下,血清中的蛋白沉淀呈现多种形态,颗粒状、絮状、带状等。
6.5.3 血清沉淀和细菌污染的区别
有些实验操作人员的经验不足,发现血清沉淀,会剧烈摇晃瓶子,希望沉淀能溶解,绝大部分情况下,沉淀不会再次溶解回血清中,此时血清沉淀变得细小,会误认为细菌污染。
血清沉淀:颗粒不均一,血清相对清澈,短时间静置后,有较明显沉降,血清无异味。
细菌污染:颗粒均一且更加微小,血清浑浊,短时间静置后不沉降,血清有明显臭味。
6.5.4 血清空培
一些实验人员,因细胞培养过程中细胞状态不好,会寻找各种试剂的原因,包括对胎牛血清空培。所谓空培,就是将血清无菌分装 5-10ml,在 37℃下放置 3天以上,观察外观变化。
空培结果分析:
· 血清明显浑浊:表示有微生物污染,这有 2 种原因,血清本身污染或者血清分装污染,需要实验人员进一步确认。
· 血清透明度下降:任何血清在 37℃下,随着时间的推移,透明度都会下降,因为血清本身是蛋白质溶液,成分复杂,会有生化反应,并不稳定。
·血清变脏:显微镜下观察,随着空培时间的增加,血清会越来越脏,这个和透明度下降是一样的道理。当然,血清在生产前增加某些物理方法的处理,会减少这种“脏”的现象。
总之,血清空培的主要作用是
观察是否有微生物污染,其它方面并没有实质意义。
6.6 胎牛血清外观异常
因采血方法、生产工艺、储存时间等不一样,各品牌的胎牛血清颜色存在较大的区别,实际上,血清的外观和质量并无直接相关性,冷冻状态下,一般来说:
· 黄色:国产胎牛血清。
· 橘黄色:国产新生牛血清。
· 淡黄色,带一点红色:澳洲胎牛胎牛血清
· 淡红色:南美胎牛血清血清。
· 颜色发暗:血红蛋白氧化,有冻融现象,融化状态越久,颜色越暗淡。
· 颜色分层:上层水样,下次颜色深,血清有自然冻融过程,如冰箱断电几天后又重新启动。
· 结晶状:血清从液态到固态的冷冻时间较长,通常 2 天以上。
· 脂质不透明状:血清从液态到固态的冷冻时间较短,如用干冰急冻。
特别注意:温度越低,血清的颜色表
现得越淡。

乌拉圭胎牛血清原料,淡红色
6.5 培养基外观异常
培养基颜色主要取决于其中的酚红,也有一些无血清培养基因添加剂特点而表现出颜色不同,我们以常规的含酚红培养基为例,保存条件是 4℃,保质期一般在 6 个月以上。
· 各种培养基颜色不同:培养基本身 pH 不同或酚红含量不同造成。
· 颜色变紫红:一般是开瓶后,在 4℃下保存越久,颜色越深,原因是碳酸盐缓冲系统中,CO2 的不断释放,导致碳酸钠比例上升,pH 升高。
· 颜色发黄:有人会把细胞培养基冷冻保存,特别是超低温冷冻,这种情况下,培养基颜色有可能从红色变为黄色,原因是酚红指示系统除了和酸碱度相关,和温度也有一定的关联性,超低温状态下的黄色,并不表明培养基酸碱度的异常,恢复到常温状态后,颜色也会恢复正常。
 开封后几天的培养基,颜色会成为紫红色
开封后几天的培养基,颜色会成为紫红色
 冷冻状态的 RPMI1640,颜色会发黄
冷冻状态的 RPMI1640,颜色会发黄




